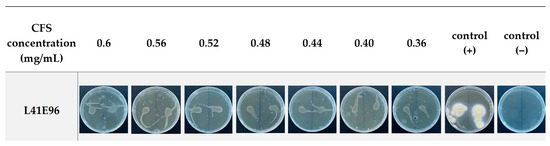

Abstract
The use of biological agents in food preservation is considered a sustainable, modern, and promising approach, in which the use of lactic acid bacteria (LAB) is a potential solution. Additionally, Vietnamese fermented cocoa beans, a naturally diverse microflora, have not yet been assessed for the selection of antifungal LAB. Therefore, this study focused on evaluating the antifungal activities against Aspergillus flavus UBOCC-A-10866 of 19 LAB strains isolated from Vietnamese fermented cocoa beans from the Dak Lak and Dong Nai provinces. The results showed that lactic strains were all capable of inhibiting fungi growth (from 18–99% of the fungal colony diameter after 7 days), of which five LAB strains (L13E48, L7E96, L22E96, L41E96, and L2DN120) were selected due to their great fungi inhibition activities (inhibition rate > 75%). The strain L41E96 (Lactiplantibacillus plantarum) was chosen as the best antifungal species with the minimum inhibitory concentration (MIC) and the minimum fungicidal concentration (MFC) of 0.36 mg/mL.
1. Introduction
Most pests and diseases that attack food crops worldwide are related to pathogenic fungal diseases. Worldwide, post-harvest losses have been estimated at 50%, with much of it being attributed to fungal infections [1]. They are found in cereals and peanuts, as well as in animal-derived foods such as dairy products and meat. The contamination can occur from sources like animal feed powder. Mold can produce several mycotoxins, especially by Aspergillus spp., Fusarium spp., and Penicillium spp., which are common mold species found in agricultural and food products [2]. Food spoilage can occur due to mold contamination at different stages of the supply chain. Mold growth can affect sensory properties and lead to health risks through mycotoxin production. Fungicides and preservative chemicals are commonly used to prevent spoilage and extend shelf life. However, government agencies are encouraging the food industry to limit its development to a natural direction. As part of this trend, there has been recent research focusing on the antifungal activities of lactic acid bacteria, which is gradually proving their potential roles in food preservation, as well as figuring out the antifungal mechanisms [3,4].
Lactic acid bacteria (LAB) consist of Gram-positive bacteria that obtain energy through the anaerobic breakdown of carbohydrates and produce lactic acid as their metabolites. They belong to the Lactobacteriaceae family, and exist in the shape of short, long, or spherical rods, or cocci. On culture plates—MRS agar, particularly—LAB form fast-growing circular colonies and are either yellowish-white or white. They can be used as the starter for a wide range of fermented foods (cheese, yogurt, fermented vegetables, cereals, etc.), probiotic products, etc. Many of them are considered GRAS (generally regarded as safe) by the FDA and EFSA. Numerous published studies have demonstrated that LAB metabolites play a crucial role in the antifungal activity of LAB. Most studies investigating LAB antifungal activities have utilized a cell-free supernatant (CFS) obtained from the bacterial culture to inhibit mold growth or culturing bacteria on agar plates coated with mold spores. These studies also demonstrated that the antifungal activities of LAB were the combined result of several mechanisms: the destabilization of the fungal cell wall, a change in the proton gradient, the production of inhibitory enzymes, and the induction of oxidative stress [5,6,7]. However, a few studies have shown competition for growth by a simultaneous culture. Previous studies have discovered a variety of antifungal compounds that are specifically created by lactic acid bacteria. These compounds can range from simple primary metabolites to more complex secondary metabolites that result from processes such as bioconversion, peptide synthesis, and protein cleavage. Primary metabolites are typically produced during the early stages of microbial development, while secondary metabolites are produced towards the later stages of growth. Most antifungal substances identified so far are low-molecular-weight compounds, which include organic acids, fatty acids, protein compounds, reuterin, hydrogen peroxide, and certain volatile substances [5]. The use of lactic acid bacteria (LAB) as antifungal preservatives has been studied on a variety of food products, including bread, dairy products, fruits, and fresh vegetables [8,9,10,11]. Hassan and Bullerman successfully used Lactobacillus paracasei spp. tolerans isolated from sourdough bread to inhibit some Penicillium and Fusarium species [8]. Similarly, the use of L. plantarum FST 1.7 and L. plantarum antifungal FST 1.9 strains in sourdough fermentation to inhibit molds such as A. niger, F. culmorum, Penicillium expansum, and P. roqueforti instead of calcium propionate was studied [12]. Fruits and vegetables with a high water content are susceptible to mold. For instance, the antifungal activity of L. plantarum CUK-501 against A. flavus, F. graminearum, Rhizopus stolonifer, and Botrytis cinerea was studied on various fresh produce [13]. These studies demonstrated that the use of antifungal LAB strains as bio-preservatives via sourdough bread technology can be a complementary addition or even a replacement for chemical preservatives.
The cocoa tree (Theobroma cacao) belongs to the Sterculiaceae family and is a popular industrial plant in tropical countries. In the process of producing cocoa beans, one of the stages that determines the quality is fermentation. The fermentation process is carried out during three main phases, characterized by a temporal succession of micro-organisms: yeast, LAB, and acetic acid bacteria [14]. Therefore, bacteria isolated from naturally fermented cocoa beans is a valuable source of microbial diversity for the selection of organic acid-producing bacteria strains such as the LAB species. The dominance of the LAB group during cocoa fermentation was presented mainly by Lactobacillus, Enterococcus, and Leuconostoc, in which Lactobacillus was the most prevalent, with L. plantarum and L. fermentum reported to be found in most regions [14].
In Vietnam, research on bio-preservatives, especially the antifungal activities of lactic acid bacteria for the selection and application in food preservation, is still limited. Moreover, despite the pre-established microbial diversity, there have not been many published studies investigating the unique characteristics of microflora in Vietnamese fermented cocoa beans. In particular, there has been no research on the application in the antifungal biological control of organic acid-producing bacteria isolated from fermented cocoa beans. Therefore, this study aims to (i) screen the anti-Aspergillus flavus activity of LAB isolated from Vietnamese fermented cocoa beans, and (ii) determine the minimum inhibitory concentration (MIC) and the minimum fungicidal concentration (MFC) of potential strains.
2. Materials and Methods
2.1. Materials
Nineteen presumptive LAB strains were isolated from Vietnamese fermented cocoa beans collected from different geographic zones of Đak Lak and Dong Nai provinces (in the Centre Highlands of Vietnam). LAB strains were isolated in MRS media (Himedia, India; adding CaCO3) presenting the white, round, evenly-edged colonies with clear CaCO3 degradation zones, negative catalase, and Gram-positive that were selected to evaluate the anti-Aspergillus flavus activity.
Aspergillus flavus UBOCC-A-10866 (Figure 1) from the Collection of Université de Bretagne occidentale (Brest, France) was used in this study as the control sample in evaluating the antifungal activity of isolated bacterial strains. This fungal strain was chosen because of its popular presence in many grains and seeds at pre- and post-harvest, which includes cocoa beans [15].

Figure 1.
Morphology of A. flavus UBOCC-A-10866 (6 days old) on YPD agar plates (left: bottom view—vegetative mycelium; right: top view—spores and aerial mycelium).
2.2. Methods
2.2.1. Micro-organism Cultivations
Presumptive LAB strains were initially kept in a 25% glycerol solution and stored at −80 °C. The strains were activated in MRS broth and inoculated at 37 °C for 24 h. After activation, the bacterial cultures were streak-plate-inoculated on MRS agar and then incubated for 48 h until bacterial colonies were observable. The bacterial agar plates were then stored in the refrigerator at 2–5 °C. Bacterial colonies on these agar plates were transferred onto new MRS agar plates every week.
A. flavus UBOCC-A-10866 were inoculated on YPD (Himedia, Mumbai, India) agar plates by spot technique [16] with slight modification (using a sharp wooden stick instead of a plastic straw) and incubated at 30 °C for 7 days until the sporulation stage. The agar plates were then stored in the refrigerator at 2–5 °C until use and transferred onto new YPD agar plates once a month.
Mold spores were directly counted using a hemocytometer [17]. The number of spores per mL of the suspension is calculated using Equation (1) below:
in which:
a: the average number of spores in a square;
Df: the dilution factor of the diluted spore suspension (with sterilized NaCl 0.9%);
h: the depth of the counting grid;
S: the total area of the square from which the average number of spores were counted;
1000: the conversion factor between mL and mm3.
2.2.2. Evaluation of Antifungal Activity of LAB in Agar Plates
LAB strains were inoculated in MRS broth and incubated at 37 °C for 12 h before refrigeration, and centrifugation at 4000 rpm and 4 °C for 10 min to separate the biomass and supernatant. The cell biomass was then collected and rinsed using NaCl 0.9%. After that, the biomass suspension was adjusted to OD600 = 0.2 (equivalent to 108 CFU/mL) using NaCl 0.9% as a blank control as well as diluent. Then, 100 μL of this biomass suspension was then inoculated on YPD agar using the spread plate method. After these agar plates were incubated at 37 °C for 24 h, 7-day-old A. flavus spores were inoculated in the center of these plates using the spot inoculation method. The agar plates were then incubated at 30 °C for 7 days. The mold colonies were observed, and the diameter of the mold colonies was measured daily, as well as the spore-forming date was recorded. YPD agar plates inoculated with only A. flavus molds were used as control samples. The antifungal activity was expressed in two parameters, the inhibition rate (IR) and the spore-forming delay (SD), and was classified according to Table 1.

Table 1.
Classification of antifungal activity based on IR and SD [18].
The inhibition rate (IR) was calculated using the Equation (2) below [18]:
in which Dcontrol is the diameter of the mold colony on the control sample plate (mm); and Dsample is the diameter of the mold colony on the test sample plate (mm).
The spore-forming delay (SD) was calculated using Equation (3) below:
in which SFcontrol is the number of days after incubation that spore was observable on the control sample plate; and SFsample is the number of days after incubation that spore was observable on the test sample plate.
The strains exhibiting a significant inhibition (IR > 75%) were then selected for further experiments.
2.2.3. Determination of the Minimum Inhibitory Concentration (MIC) and the Minimum Fungicidal Concentration (MFC) of LAB’s Cell-Free Supernatant (CFS)
- Preparation of CFS
LAB was activated twice by inoculation in MRS broth for 24 h, then centrifuged at 10,000 rpm, and 4 °C for 10 min to collect the supernatant. After centrifugation, the supernatant was then filtered through a 0.22 μm filter for obtaining CFS (the density of CFS was 1.012 ± 0.006 mg/mL).
- Determination of the minimum inhibitory concentration (MIC) and the minimum fungicidal concentration (MFC)
The MIC value of CFS was determined by the microdilution method utilizing the 96-well microplates [19,20]. A total volume of 200 μL solution consisting of 120 μL lactic bacteria CFS (diluted with sterilized water to reached the final CFS concentration in wells at approximately 0.6; 0.56; 0.52; 0.48; 0.44; 0.40; 0.36; 0.32; 0.28; and 0.24 mg/mL), 20 μL of spore suspension (105 spores/mL), and 60 μL of YPD broth was added to each microwell so that the final spore density of all microwells was 104 spores/mL. Positive control microwell contained the following: 60 μL of YPD broth, 120 μL sterile distilled water, and 20 μL spore suspension. Negative control microwell contained the following: 60 μL of YPD broth and 140 μL sterile distilled water. The 96-well microplates were incubated at 30 °C for 5 days for observation. The growth of fungi on all microwells was then observed to determine the microwells without visible fungal growth. As mentioned above, the concentration of bacterial CFS in the microwell in which there was no visible fungal growth was the minimum inhibitory concentration—MIC value.
To determine the MFC value, 10 μL of the concentration corresponding to the MIC and higher concentrations evaluated were spread on YPD agar plates (with 0.5 μg/L streptomycin supplement). The cultures were then incubated again at 30 °C for 3 days for observation. The MFC value was determined as the concentration of CFS that avoided any visible fungal growth of the recultivated culture [21].
2.2.4. pH, Total Titratable Acidity, and Organic Acid Profile in CFS
pH of CFS was measured by pHmeter (Orion Star A211—Thermo Scientific-Waltham, MA, USA). Total titrable acidity was determined by neutralization method with NaOH 0.1 N (phenolphthalein indicator) and expressed as lactic acid equivalent (g/L).
Organic acid profile of CFS was quantified by HPLC. CFS after filtering by 0.20 μm membrane was injected in Aminex HPX-87H column (Bio-Rad, Hercules, CA, USA), RID detector, mobile phase H2SO4 10 mM, flow rate 0.5 mL/min, and 60 °C in 30 min. Lactic acid, acetic acid, propionic acid, butyric acid, and formic acid were used as standards. MRS media was sterilized and used as a blank.
2.2.5. Strain Identification
The isolated LAB strains were identified based on sequences of 16S rRNA gene sequences as followed. Genomic DNAs were isolated using the CTAB protocol as described in William S et al. (2012) [22]. The 16S rRNA gene was amplified using universal bacterial primer pairs 27F and 1492R and Gotaq® Green Master Mix 2X (Promega, Madison, WI, USA). The sequence of 16S rRNA gene amplification products were revealed by Sanger sequencing (Apical Scientific sequencing, Singapore). The identities of the isolates were inferred from BLASTN results on the NCBI database.
2.2.6. Statistical Analysis
The means and standard deviations were determined for the measurements from at least three replicates. The significant difference of mean values was assessed with one-way analysis of variance (ANOVA) followed by Tukey’s test using SPSS 20 software at a significance level of p < 0.05.
3. Results and Discussion
3.1. Evaluation of Antifungal Activity of LAB Strains on the Agar Plates
The cell biomass after the refrigerated centrifugation of 19 presumptive LAB strains was tested for antifungal activity against A. flavus UBOCC-A-108066 in this experiment. Figure 2 shows the mold growth under the inhibitory effect of different LAB strains within 7 days of incubation. Regarding the control, A. flavus UBOCC-A-108066 formed fast-growing colonies of white color, which gradually turned yellowish, greenish, or brownish due to spore formation in the later days. The diameters of these colonies increased from slightly to significantly every day, varying among inoculated LAB species. Nevertheless, the diameters of mold colonies in all agar plates inoculated with the bacterial cell biomass were visually smaller, by varying degrees, compared to those of the control. Moreover, in most agar plates inoculated with the bacterial cell biomass, the spore-forming process (observed by a color change) was also delayed compared to the blank control. Especially, negligible to no mold growth, or no evidence of spore-forming, was observed for several test samples, namely, the L13E48, L7E96, L22E96, L41E96, and L2DN120 species. Therefore, these results indicated that the cell biomass of different LAB species exerted different degrees of fungal inhibition in competitive growth with mold, which agreed with the result of Volentini et al. in a previous study on lemon post-harvest preservation by LAB [11].

Figure 2.
Growth of A. flavus UBOCC-A-108066 within 7 days of co-incubation with different LAB species on YPD agar plates (image for 10/19 LAB strains).
Based on the inhibition rate (IR), 13 out of 19 LAB strains were categorized as exerting negligible to low inhibition activities (reducing the diameters of mold growth up to 50%) (Table 2). On the other hand, 6 strains showed high to significant degrees of inhibition activities against mold growth (reducing the diameters of mold growth by over 50%). Out of these 6 species, L13E48, L7E96, L22E96, and L2DN120 were capable of inhibiting mold growth to over 97% by diameter.

Table 2.
Evaluating the antifungal activities of different LAB strains ((-): negligible inhibition, (+): low inhibition, (++): high inhibition, and (+++): significant inhibition).
There were very limited previous studies on the antifungal activity of LAB species against A. flavus, evaluating the inhibition rate based on the mold colony diameter. However, the results for other fungi inhibitions also strengthened our observation. Mpeluza A et al. (2023) studied the antifungal activity of LAB species against Colletotrichum gloeosporioides and found that several strains can inhibit mold growth from 80.34% up to 100% [23]. Moreover, Riolo M et al. (2023) conducted a study comparing the antifungal activity shown by LAB species against pathogenic isolates, in which two C. gloeosporioides species (RD9B and C2) showed a much higher susceptibility towards LAB strains compared to A. flavus [24].
Regarding the spore-forming delay (SD), 12 out of 19 strains have negligible or low inhibitory effects (with only a delay of up to 2 days of the spore-forming process). On the other hand, the other 7 species could delay the process for more than 3 days, with some exceptional species that completely delayed spore-forming throughout the whole 7 days, namely, the L7E96, L22E96, L41E96, L13E48, and L2DN120 strains.
Therefore, based on the evaluated criteria, five LAB strains, including L7E96, L22E96, L41E96, L13E48, and L2DN120 had the best antifungal activities. The 16S rRNA gene sequences revealed the identities of L41E96, L13E48, and L2DN120, those isolates being Lactiplantibacillus plantarum, Limosilactobacillus fermentum, and Lacticaseibacillus paracasei, respectively, whereas L7E96 and L22E96 belonged to the Levilactobacillus brevis species. These species were isolated from fermented cocoa beans in the Eakar district (Dak Lak province) and Dinh Quan district (Dong Nai province), which may propose a hypothesis that geographical origin does not necessarily have a connection with the antifungal activity of LAB species, particularly in the context of this study. These species were selected for an analysis of the cell-free supernatant (CFS) in the next experiment.
3.2. The Minimum Inhibitory Concentration and the Minimum Fungicidal Concentration of LAB’s Cell-Free Supernatant
3.2.1. pH, Total Titratable Acidity, and Organic Acid Profile of CFS
The pH values of CFS varied among different LAB strains (Table 3). The CFS of the L41E96 species had the lowest pH of 3.80 ± 0.03, whereas the pH of L22E96’s CFS was the highest, at 4.37 ± 0.02. Similarly, for the total titratable acidity, L13E48 and L41E96 produced the most and the least acid, at 12.75 ± 0.26 and 21.45 ± 0.52 g/L, respectively. If based on the antifungal mechanism of organic acids, these huge differences in the acidity degrees could be the explanation for varying antifungal activities of the selected LAB strains.

Table 3.
pH and total titrable acidity of LAB’s CFS.
Considering the organic acid profile in CFS, several acids such as lactic acid, acetic acid, propionic acid, and butyric acid were detected at different concentrations (Table 4). These organic acids are the antifungal metabolites previously demonstrated in the literature, which can explain the anti-Aspergillus flavus of the tested strains [5,6]. All the CFS contained a large amount of lactic acid, which ranged from 12.3889 g/L up to 24.8859 g/L of the L13E48 and L41E96 strains, respectively. This aligns with the findings of Russo et al. (2017) [25], who demonstrated that the lactic acid levels produced by two L. plantarum strains increased exponentially and reached about 25 g/L after 24 h [10]. Meanwhile, the L2DN120 strain produced the most acetic acid (0.4941 g/L), and L7E96 produced the most propionic acid (0.4941 g/L). However, only L22E96, L13E48, and L2DN120 could produce butyric acid, and no strain could produce formic acid. By comparing the inhibition rate and the spore-forming delay (Table 2) with the organic acid profiles, it is hard to find significant correlations between these two parameters. Therefore, undetected organic acids and/or other metabolites such as fatty acids, proteinaceous compounds, acids derived from amino acids, volatiles, etc. could have contributed to the antifungal activities of these selected LAB strains.

Table 4.
Organic acid profile of LAB’s CFS.
3.2.2. Minimum Inhibitory Concentration and Minimum Fungicidal Concentration
The growth of mold on the 96-well plate after five days is shown in Figure 3. In the negative control, no mold growth was observed, while A. flavus formed yellowish-green mycelium on the surface of the positive control well. For the four strains L7E96, L22E96, L13E48, and L2DN120, mold growth appeared at the tested concentrations, which proves that the MIC of these strains were all higher than 0.6 mg/mL. In contrast, for strain L41E96, no mold growth was observed in the wells with CFS concentrations from 0.6 mg/mL to 0.36 mg/mL, leading to the conclusion that the minimum inhibitory concentration for A. flavus (104 spores/mL) of L41E96 is 0.36 mg/mL. Next, to determine the minimum fungicidal concentration (MFC), 10 μL of the culture from the wells containing L41E96 (where no mold growth was observed) was inoculated onto YPD agar and incubated at 30 °C for 3 days; the results are shown in Figure 4. No mold growth was observed on any of the inoculated agar plates, except for the positive control. Therefore, for strain L41E96, the MFC was the same as the MIC of 0.36 mg/mL. These results are consistent with those from a previous study on the antifungal activity of lactic acid bacteria, which showed that the MIC of seven L. plantarum strains against 5 × 103 spores/mL of A. flavus ITEM 8111 ranged from 0.062 to 0.250 mg/mL and the MFC was 0.250 mg/mL [21].

Figure 3.
Growth of A. flavus UBOCC-A-108066 in 96-well microplates after 5 days of incubation.
Figure 4.
Growth of mold culture from microwells inoculated on YPD agar plates after 5 days of incubation.
4. Conclusions
The study evaluated the antifungal activity of 19 lactic acid bacteria strains isolated from fermented Vietnamese cocoa beans. Five lactic acid bacteria strains were selected, L13E48, L7E96, L22E96, L41E96, and L2DN120, for their strong anti-Aspergillus flavus UBOCC-A-108066 activity during competitive cultivation on YPD agar. These species inhibited mold growth of up to 95% of the diameter of the fungal colony and delayed the spore formation by up to 5 days within 7 days of incubation. The cell-free supernatant of these strains was evaluated, thereby determining the minimum inhibitory and minimum fungicidal concentrations of strain L41E96 at 0.36 mg/mL. The 16S rRNA gene sequences revealed the identities of L41E96, L13E48, and L2DN120, those isolates being Lactiplantibacillus plantarum, Limosilactobacillus fermentum, and Lacticaseibacillus paracasei, respectively, whereas L7E96 and L22E96 belonged to the Levilactobacillus brevis species. This opens up the potential for application in the biological control of mold in the preservation of agricultural products and foods.
Author Contributions
Investigation: T.C.N., T.T.H. and H.H.N.; writing—original draft preparation, T.C.N. and H.H.N.; and writing—review and editing, T.C.N. All authors have read and agreed to the published version of the manuscript.
Funding
This research is funded by the Ministry of Education and Training of Vietnam under grant number B2024-BKA-07.
Institutional Review Board Statement
Not applicable.
Informed Consent Statement
Not applicable.
Data Availability Statement
Data is contained within the article.
Conflicts of Interest
The authors declare no conflicts of interest.
References
- Magro, A.; Carolino, M.; Bastos, M.; Mexia, A. Efficacy of plant extracts against stored products fungi. Rev. Iberoam. Micol. 2006, 23, 176–178. [Google Scholar] [CrossRef] [PubMed]
- Bullerman, L.B. SPOILAGE | Fungi in Food—An Overview. In Encyclopedia of Food Sciences and Nutrition; Academic Press: Cambridge, MA, USA, 2003; pp. 5511–5522. [Google Scholar] [CrossRef]
- Gacem, M.A.; Krantar, K.; Hadef, S.; Boudjemaa, B. Chapter 6—Secondary metabolites from lactic acid bacteria as a source of antifungal and antimycotoxigenic agents. In Bacterial Secondary Metabolites; Abd-Elsalam, K.A., Mohamed, H.I., Eds.; Elsevier: Amsterdam, The Netherlands, 2024; pp. 107–122. [Google Scholar]
- Zhang, Y.; Li, B.; Fu, M.; Wang, Z.; Chen, K.; Du, M.; Zalán, Z.; Hegyi, F.; Kan, J. Antifungal mechanisms of binary combinations of volatile organic compounds produced by lactic acid bacteria strains against Aspergillus flavus. Toxicon 2024, 243, 107749. [Google Scholar] [CrossRef] [PubMed]
- Shi, C.; Maktabdar, M. Lactic Acid Bacteria as Biopreservation Against Spoilage Molds in Dairy Products—A Review. Front. Microbiol. 2022, 12, 819684. [Google Scholar] [CrossRef]
- Siedler, S.; Balti, R.; Neves, A.R. Bioprotective mechanisms of lactic acid bacteria against fungal spoilage of food. Curr. Opin. Biotechnol. 2019, 56, 138–146. [Google Scholar] [CrossRef]
- Muhialdin, B.J.; Algboory, H.L.; Kadum, H.; Mohammed, N.K.; Saari, N.; Hassan, Z.; Meor Hussin, A.S. Antifungal activity determination for the peptides generated by Lactobacillus plantarum TE10 against Aspergillus flavus in maize seeds. Food Control 2020, 109, 106898. [Google Scholar] [CrossRef]
- Hassan, Y.I.; Bullerman, L.B. Antifungal activity of Lactobacillus paracasei ssp. tolerans isolated from a sourdough bread culture. Int. J. Food Microbiol. 2008, 121, 112–115. [Google Scholar] [CrossRef]
- Le Lay, C.; Mounier, J.; Vasseur, V.; Weill, A.; Le Blay, G.; Barbier, G.; Coton, E. In vitro and in situ screening of lactic acid bacteria and propionibacteria antifungal activities against bakery product spoilage molds. Food Control 2016, 60, 247–255. [Google Scholar] [CrossRef]
- Rouse, S.; Harnett, D.; Vaughan, A.; van Sinderen, D. Lactic acid bacteria with potential to eliminate fungal spoilage in foods. J. Appl. Microbiol. 2008, 104, 915–923. [Google Scholar] [CrossRef]
- Volentini, S.I.; Olmedo, G.M.; Grillo-Puertas, M.; Rapisarda, V.A.; Hebert, E.M.; Cerioni, L.; Villegas, J.M. Biological control of green and blue molds on postharvest lemon by lactic acid bacteria. Biol. Control 2023, 185, 105303. [Google Scholar] [CrossRef]
- Ryan, L.A.M.; Dal Bello, F.; Arendt, E.K. The use of sourdough fermented by antifungal LAB to reduce the amount of calcium propionate in bread. Int. J. Food Microbiol. 2008, 125, 274–278. [Google Scholar] [CrossRef]
- Agriopoulou, S.; Stamatelopoulou, E.; Sachadyn-Król, M.; Varzakas, T. Lactic Acid Bacteria as Antibacterial Agents to Extend the Shelf Life of Fresh and Minimally Processed Fruits and Vegetables: Quality and Safety Aspects. Microorganisms 2020, 8, 952. [Google Scholar] [CrossRef] [PubMed]
- Viesser, J.A.; de Melo Pereira, G.V.; de Carvalho Neto, D.P.; Favero, G.R.; de Carvalho, J.C.; Goés-Neto, A.; Rogez, H.; Soccol, C.R. Global cocoa fermentation microbiome: Revealing new taxa and microbial functions by next generation sequencing technologies. World J. Microbiol. Biotechnol. 2021, 37, 118. [Google Scholar] [CrossRef] [PubMed]
- Sánchez-Hervás, M.; Gil, J.V.; Bisbal, F.; Ramón, D.; Martínez-Culebras, P.V. Mycobiota and mycotoxin producing fungi from cocoa beans. Int. J. Food Microbiol. 2008, 125, 336–340. [Google Scholar] [CrossRef] [PubMed]
- Fusaro Ramon, M. Inoculation Technique for Fungus Cultures. Appl. Microbiol. 1972, 23, 174–176. [Google Scholar] [CrossRef]
- Gopalakrishnan, S.; Arigela, R.; Thyagarajan, S.; Raghunathan, R. Comparison and evaluation of enumeration methods for measurement of fungal spore emission. J. Aerosol Sci. 2022, 165, 106033. [Google Scholar] [CrossRef]
- Plascencia-Jatomea, M.; Susana, M.; Gómez, Y.; Velez-Haro, J.M. Chapter 8—Aspergillus spp. (Black Mold). In Postharvest Decay; Bautista-Baños, S., Ed.; Academic Press: San Diego, CA, USA, 2014; pp. 267–286. [Google Scholar]
- Harčárová, M.; Čonková, E.; Naď, P.; Váczi, P.; Proškovcová, M. In Vitro Inhibitory Activity of Cell-Free Supernatants of Lactobacillus spp. and Bacillus spp. Against Fusarium graminearum. Folia Vet. 2021, 65, 9–14. [Google Scholar] [CrossRef]
- Liu, H.; Zhang, R.; Zhang, Q.; Tian, M.; Ren, X.; Wang, L.; Wang, X. Antifungal Activity of Cell-Free Supernatants from Lactobacillus pentosus 86 against Alternaria gaisen. Horticulturae 2023, 9, 911. [Google Scholar] [CrossRef]
- Nazareth, T.M.; Luz, C.; Torrijos, R.; Quiles, J.M.; Luciano, F.B.; Mañes, J.; Meca, G. Potential Application of Lactic Acid Bacteria to Reduce Aflatoxin B1 and Fumonisin B1 Occurrence on Corn Kernels and Corn Ears. Toxins 2019, 12, 21. [Google Scholar] [CrossRef]
- William, S.; Feil, H.; Copeland, A. Bacterial Genomic DNA Isolationg Using CTAB; Version 3; JGI DOE Joint Genome Institute: Berkeley, CA, USA, 2012. Available online: https://scholar.google.com/scholar_lookup?title=Bacterial+genomic+DNA+isolation+using+CTAB&author=S+William&author=H+Feil&author=A+Copeland&publication_year=2012&journal=Sigma&pages=6876 (accessed on 7 April 2025).
- Mpeluza, A.S.; Akinola, S.A.; Shoko, T.; Remize, F.; Sivakumar, D. Efficacy of Lactic Acid Bacteria as a Biocontrol Agent against Anthracnose (Persea americana Miller) Decay in Avocado (Persea americana) cv Fuerte Fruit. Agriculture 2023, 13, 269. [Google Scholar] [CrossRef]
- Riolo, M.; Luz, C.; Santilli, E.; Meca, G.; Cacciola, S.O. Antifungal activity of selected lactic acid bacteria from olive drupes. Food Biosci. 2023, 52, 102422. [Google Scholar] [CrossRef]
- Russo, P.; Arena, M.P.; Fiocco, D.; Capozzi, V.; Drider, D.; Spano, G. Lactobacillus plantarum with broad antifungal activity: A promising approach to increase safety and shelf-life of cereal-based products. Int. J. Food Microbiol. 2017, 247, 48–54. [Google Scholar] [CrossRef]
Disclaimer/Publisher’s Note: The statements, opinions and data contained in all publications are solely those of the individual author(s) and contributor(s) and not of MDPI and/or the editor(s). MDPI and/or the editor(s) disclaim responsibility for any injury to people or property resulting from any ideas, methods, instructions or products referred to in the content. |
© 2025 by the authors. Licensee MDPI, Basel, Switzerland. This article is an open access article distributed under the terms and conditions of the Creative Commons Attribution (CC BY) license (https://creativecommons.org/licenses/by/4.0/).